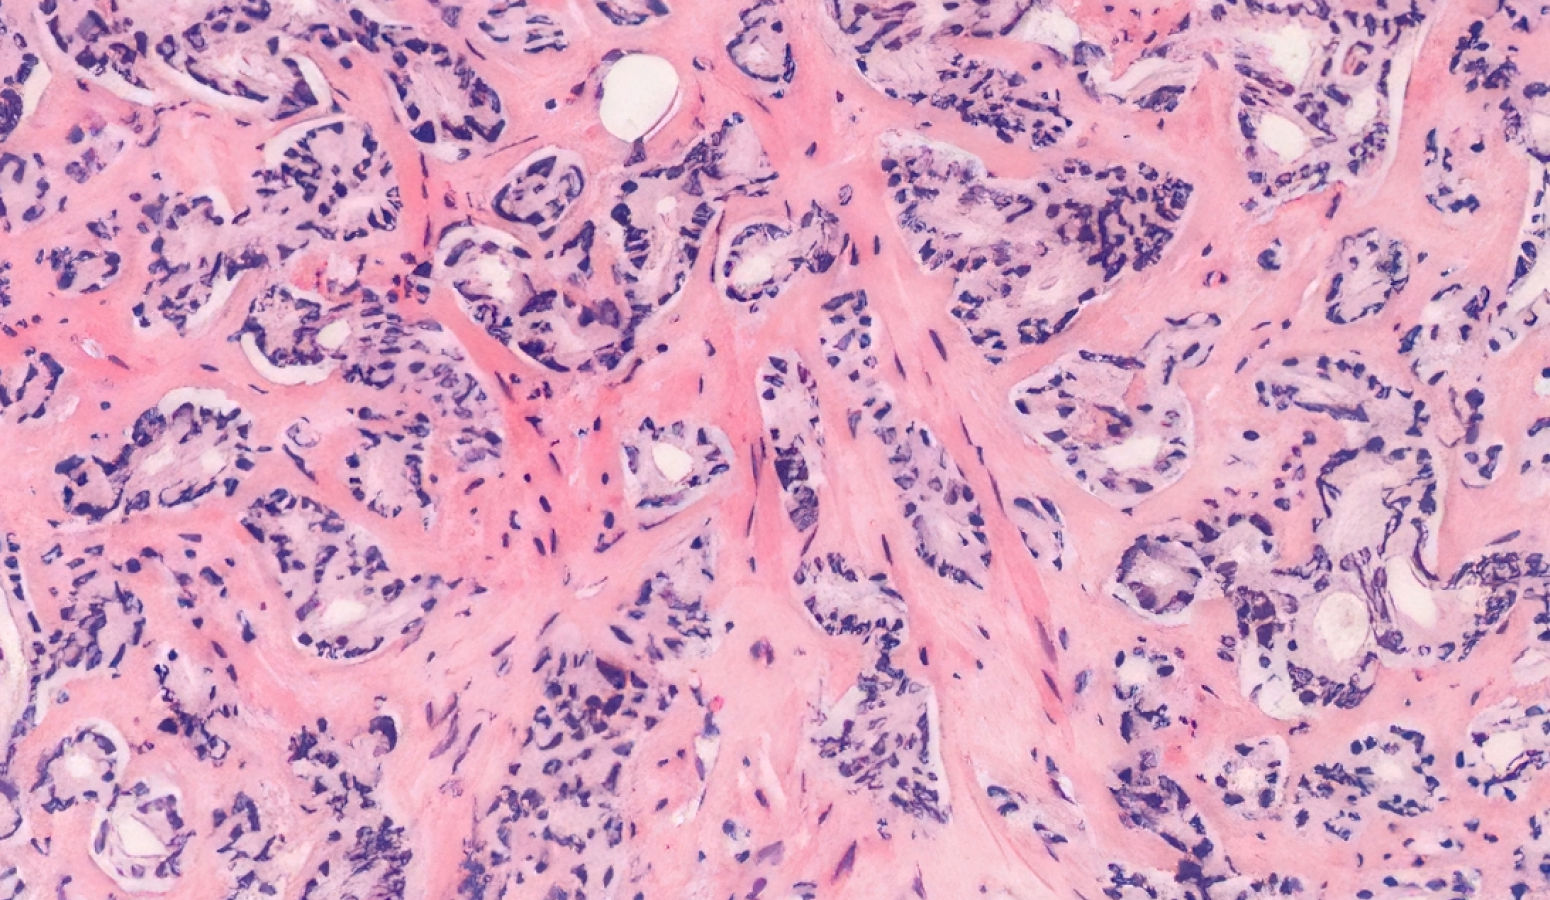
전립선암 조직

boraware active



AI CURATION
스마트한 골드만 AI에게
당신의 증상을 간단히 써주세요.
- ex) 소변이 자주 마렵고 항상 잔뇨감이 있어요
- ex) 소변 볼 때 화끈거리는 통증이 있어요
- ex) 성기에 물집이 생겼는데 간지럽고 따가워요
초기 증상이 거의 없어 정기검진이 매우 중요한 고위험 질환입니다.
무통마취 및 AI 기반 MRI 표적 조직검사로 빠르고 정확히 진단하고, 방사선 치료 합병증 등 수술 후 관리 또한 체계적으로 진행합니다.
골드만은 빠르고 정확한 진단을 약속합니다.
정기검진과 정확한 진단이 생존율과 치료 결과를 좌우합니다.
SINCE 2002, AI 스마트 의료의 중심
SINCE 2002, AI 스마트 의료의 중심
SINCE 2002, AI 스마트 의료의 중심
SINCE 2002, AI 스마트 의료의 중심
이런 비정상 세포가 악성 종양을 만들고, 전립선에 생기면 전립선암이 됩니다.
-
전립선 정상 조직

-
전립선암 조직
조용히 다가오는 위험 신호
초기에는 증상이 거의 없어 자각이 어려운 만큼, 정기적인 검진을 통한 조기 발견이 필수입니다.
노령 인구의 증가와 여러 진단 방법의 발달도 발병률 증가의 요인이 되고 있습니다.
-
 노화 및 남성 호르몬의 변화나이가 들수록 발생이 증가하며
노화 및 남성 호르몬의 변화나이가 들수록 발생이 증가하며
남성호르몬이 성장에 영향을 줍니다. -
 유전적 요인가족 중 전립선암 병력이 있는 경우
유전적 요인가족 중 전립선암 병력이 있는 경우
발병 위험이 높아질 수 있습니다.
-
 생활습관 요인운동 부족, 고지방 식단, 비만, 음주 등은 전립선 건강을 악화시키고
생활습관 요인운동 부족, 고지방 식단, 비만, 음주 등은 전립선 건강을 악화시키고
전립선암 발생 위험을 높이는 요인으로 알려져 있습니다. -
 배뇨 기능 장애비정상적인 배뇨 움직임과 소변 잔류, 요역류가
배뇨 기능 장애비정상적인 배뇨 움직임과 소변 잔류, 요역류가
전립선염을 유발하거나 악화시킵니다.
-
 면역학적 반응세균 없이 면역 반응이 전립선 염증을 유발하며
면역학적 반응세균 없이 면역 반응이 전립선 염증을 유발하며
이는 비세균성 전립선염의 주요 원인입니다. -
 신경계 민감화신경 과민으로 염증 없이도 전립선 통증이
신경계 민감화신경 과민으로 염증 없이도 전립선 통증이
지속될 수 있습니다. -
 심리적 요인스트레스와 긴장은 전립선 근육과 신경을 자극해 통증을 악화시키고, 골반저근육 과긴장은 만성 골반통을 유발합니다.
심리적 요인스트레스와 긴장은 전립선 근육과 신경을 자극해 통증을 악화시키고, 골반저근육 과긴장은 만성 골반통을 유발합니다.

정기검진으로 인한 조기발견, 최적의 시기에 치료 진행, 재발방지를 위한 수술 후 관리로 이 모든 것을 고려해야 합니다.
-
국소성 전립선암 치료
 STEP 01암이 전립선 내에 한정된 경우,
STEP 01암이 전립선 내에 한정된 경우,
부작용을 최소화하며 수술로 완치를 목표로 합니다. -
국소 전이된 전립선암 치료
 STEP 02암이 전립선을 벗어났지만 림프절 등 다른 부위로 전이되지 않은 상태로 수술, 방사선, 호르몬 치료를 병행해 치료 효과를 높입니다.
STEP 02암이 전립선을 벗어났지만 림프절 등 다른 부위로 전이되지 않은 상태로 수술, 방사선, 호르몬 치료를 병행해 치료 효과를 높입니다. -
전이 전립선암 치료
 STEP 03암이 주변 장기, 림프절, 뼈 등으로 전이된 상태로 완치가 어려운 단계입니다. 이때는 진통제, 항암제, 방사선, 호르몬 억제 치료 등을 시행합니다.
STEP 03암이 주변 장기, 림프절, 뼈 등으로 전이된 상태로 완치가 어려운 단계입니다. 이때는 진통제, 항암제, 방사선, 호르몬 억제 치료 등을 시행합니다.
어떻게 진행되나요?
수술, 방사선, 호르몬 치료 등 환자 상태에 맞춘 맞춤형 치료가 중요합니다.
수술 후 관리가 핵심입니다.
부작용과 재발을 막기 위한 체계적인 추적관찰과 사후관리를 제공합니다.
-
Step
정기검진으로 인한 조기발견 -
Step
최적의 시기에 치료 진행 -
Step
재발방지 및 부작용 최소화를 위한 수술 후 관리


It’s Advanced! 전립선암 치료,
골드만이 앞서가는 이유 BIG 5
누구나 치료는 하지만 정확히 진단하고 다르게 치료하는 곳은 드뭅니다.
골드만은 원인을 놓치지 않는 진단과 풍부한 치료 경험으로 결과를 만듭니다.
-
네, 50대 이후부터 발생률이 급격히 높아지며 특히 70대 이상에서 많이 발생합니다. 가족력, 식습관, 비만 등도 위험 요인입니다.
-
아닙니다. 진행이 느리고 분화도가 좋은 경우에는 적극적인 치료 대신 관찰(기대요법)을 선택하기도 합니다. 그러나 이는 환자의 건강 상태와 병기에 따라 달라집니다.
-
수술(전립선 적출술), 방사선 치료, 호르몬 치료, 기대요법 등 여러 방법이 있으며 암의 진행 정도와 환자의 건강 상태에 따라 맞춤 치료가 결정됩니다.
-
대표적으로 요실금과 발기부전이 있을 수 있으며 수술 전 충분한 상담과 수술 후 부작용을 최소화 하기 위한 회복 프로그램이 필요합니다.
-
학회 및 발표국제 비뇨의학 교류 활발… 조정호 원장, 일본 JSER 2026 학회에서 워터젯 수술 강연2025. 12. 05
-
학회 및 발표골드만 의료진, SIU 2025 국제비뇨의학회 학술 발표 및 참석 보고2025. 11. 18
-
학회 및 발표국내 최대 비뇨의학 학술대회, 골드만 의료진 KUA 2025 참석2025. 10. 28
-
학회 및 발표전립선비대증 수술의 새로운 패러다임, 골드만 의료진 KPS BTS 학술대회 발표2025. 09. 30
-
신기술 도입전립선비대증 신의료기술, 아이틴드 시술 공식 인증 및 심포지엄 발표 진행2025. 08. 13
-
 오직 비뇨질환만
오직 비뇨질환만25년
1 -
 독보적 치료데이터
독보적 치료데이터200만건+
2 -
 비대증 수술 데이터
비대증 수술 데이터6천 건+
3 -
 요로결석 치료 데이터
요로결석 치료 데이터1만 건+
4 -
 전국 홀렙수술
전국 홀렙수술약 40% 집도
5 -
 경험 많은 의료진
경험 많은 의료진25년 임상경력
6 -
 진단부터 수술까지
진단부터 수술까지최첨단 AI 시스템
7


















![골드만비뇨의학과 전립선암, 환자들이 가장 많이 묻는 질문 모음! 전립선암 Q&A 총정리 [김광현 교수님 초청 전립선암 5편]](/_File/videoTalk//y_Zv6FjnMdZMQ.jpg)
![골드만비뇨의학과 이 내용 꼭 알고가세요! 전립선암 치료방법과 특징 [김광현교수님 초청 전립선암 3편]](/_File/videoTalk//y_bFOIG-7yS4I.jpg)
![골드만비뇨의학과 전립선암 검사, 대학병원에서는 어떤 검사를? 검사 대기가 길어지는 요즘 개원가 병원의 역할은? [김광현교수님 초청 전립선암 2편]](/_File/videoTalk//y_oE00mvnybQk.jpg)
![골드만비뇨의학과 비정상토크 1호 게스트 김광현 교수님과 함께하는 전립선암 토크, 전립선암에 대해 자세하게 파헤쳐드립니다! [김광현교수님 초청 전립선암 1편]](/_File/videoTalk//y_7E8YnKf2aEY.jpg)

![골드만비뇨의학과 [전립선 조직검사 2편] MRI랑 초음파를 융합해서 전립선암을 진단한다? 진단율을 높이는 MRI 초음파 융합 전립선 조직검사!](/_File/videoTalk//y_RuGpGNpXL6A.jpg)
![골드만비뇨의학과 [전립선 조직검사 1편] 남성암 발생률 2위? 전립선암 진단을 위한 전립선 조직검사에 대해 알려드립니다!](/_File/videoTalk//y_rbZpoSnfEB8.jpg)

